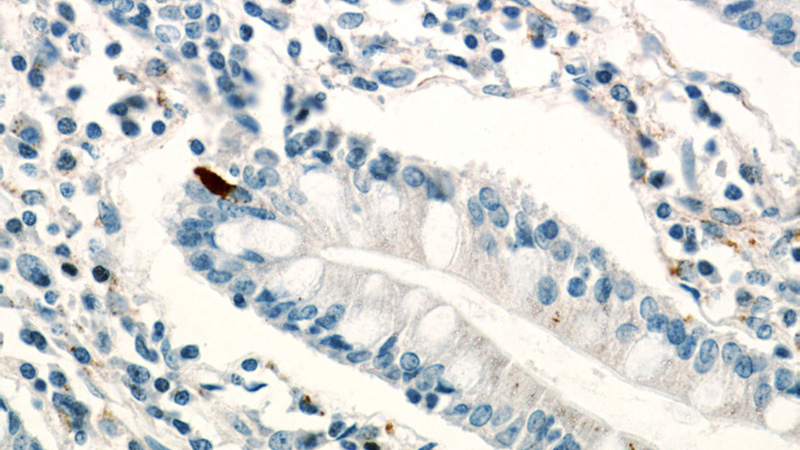
Immunohistochemical of paraffin-embedded human small intestine using Catalog No:112211(LGR5 antibody) at dilution of 1:200 (under 40x lens)

-
Product Name
LGR5 antibody
- Documents
-
Description
LGR5 Rabbit Polyclonal antibody. Positive IHC detected in human small intestine tissue, human colon cancer tissue, human colon tissue, human liver cancer tissue.
-
Tested applications
ELISA, IHC
-
Species reactivity
Human; other species not tested.
-
Alternative names
FEX antibody; G protein coupled receptor 49 antibody; G protein coupled receptor 67 antibody; GPR49 antibody; GPR67 antibody; GRP49 antibody; HG38 antibody; LGR5 antibody
-
Isotype
Rabbit IgG
-
Preparation
This antibody was obtained by immunization of LGR5 recombinant protein (Accession Number: NM_003667). Purification method: Antigen affinity purified.
-
Clonality
Polyclonal
-
Formulation
PBS with 0.02% sodium azide and 50% glycerol pH 7.3.
-
Storage instructions
Store at -20℃. DO NOT ALIQUOT
-
Applications
Recommended Dilution:
IHC: 1:20-1:200
-
Validations

Immunohistochemical of paraffin-embedded human small intestine using Catalog No:112211(LGR5 antibody) at dilution of 1:200 (under 10x lens)
Immunohistochemical of paraffin-embedded human small intestine using Catalog No:112211(LGR5 antibody) at dilution of 1:200 (under 40x lens)
-
Background
LGR5, also named as GPR49, GPR67 and HG38, belongs to the G-protein coupled receptor 1 family. It is an orphan receptor. LGR5 is a stem cell marker of the intestinal epithelium and the hair follicule. It is a target gene of Wnt signaling.
-
References
- Wang Y, Jiang CQ, Fan LF. Correlation of Musashi-1, Lgr5, and pEGFR expressions in human small intestinal adenocarcinomas. Tumour biology : the journal of the International Society for Oncodevelopmental Biology and Medicine. 36(8):6075-82. 2015.
- Vieira GC, Chockalingam S, Melegh Z. LGR5 regulates pro-survival MEK/ERK and proliferative Wnt/β-catenin signalling in neuroblastoma. Oncotarget. 6(37):40053-67. 2015.
Related Products / Services
Please note: All products are "FOR RESEARCH USE ONLY AND ARE NOT INTENDED FOR DIAGNOSTIC OR THERAPEUTIC USE"
